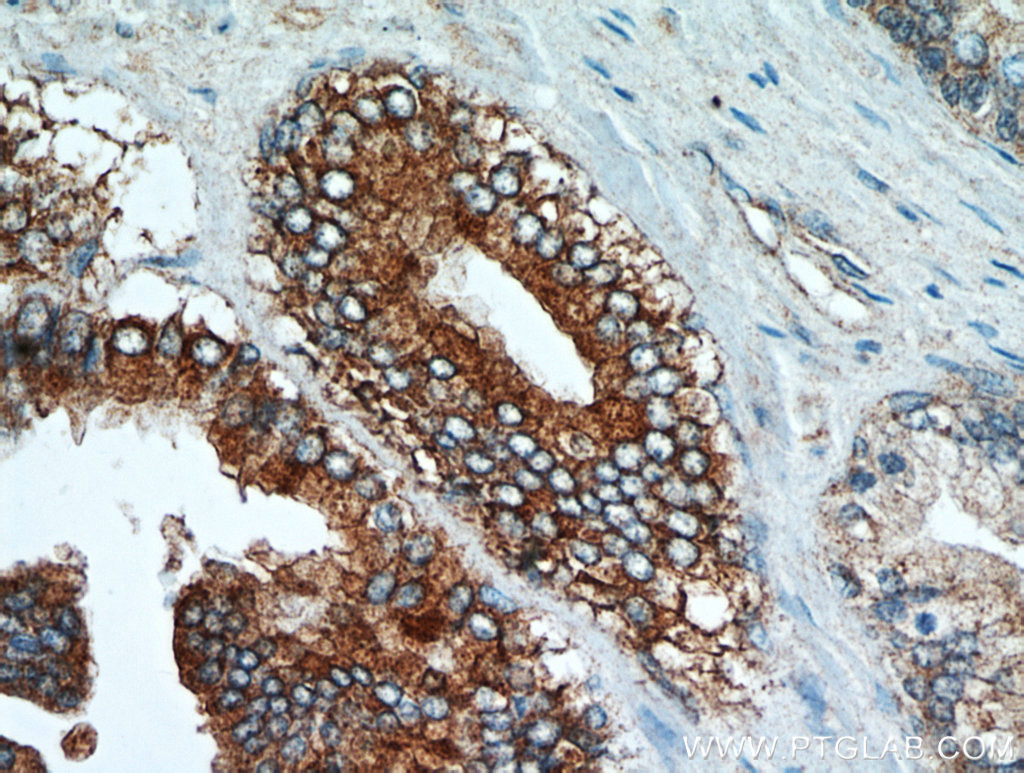
NEDD4L Antibody 136901AP Proteintech

NEDD4L(Neural precursor cell expressed developmentally downregulated gene 4-like)またはNEDD4-2は、NEDD4ファミリーに属する酵素(ユビキチンリガーゼ)である。ヒトではNEDD4L遺伝子にコードされる。マウスでは、NEDD4-2、Nedd4-2遺伝子として一般的に知られている。
NEDD4-2は、腎臓の集合管において上皮性ナトリウムチャネル(ENaC)をユビキチン化してダウンレギュレーションし、アルドステロンの作用に拮抗して塩類の排出を増加させることが示されている。リドル症候群ではNEDD4LはENaCに結合することができず、塩類の貯留と高血圧が引き起こされる。
NEDD4Lは、E3HECTドメインユビキチンリガーゼのNEDDファミリーに属する。NEDD4Lは、このファミリーのプロトタイプであるNEDD4に最も近縁なホモログであり、おそらく遺伝子重複の結果生じたものである。NEDD4のオルソログはすべての真核生物に存在する一方、NEDD4Lタンパク質は脊椎動物に限られている。NEDD4Lタンパク質は、多くの膜タンパク質のユビキチン化とエンドサイトーシスを介した調節に関与していることが知られている。
NEDD4Lタンパク質は広く発現している。NEDD4-2の主要な標的にはENaC、Na /Cl-共輸送体(NCC)、電位依存性ナトリウムチャネル(Nav)が含まれるが、他の標的はin vitroでの研究から予測されたものである。マウスのNedd4-2遺伝子は生存に必須であり、ヒトではNEDD4Lの多型は高血圧と関係している。
タンパク質構造
NEDD4Lタンパク質は、N末端のC2ドメイン(Ca2 -リン脂質結合ドメイン)、4つのWWドメイン(タンパク質-タンパク質相互作用ドメイン)、C末端のHECTドメイン(ユビキチンリガーゼドメイン)から構成される。WWドメインが基質、調節タンパク質、アダプタータンパク質との結合を担う。これらのドメインは一般的に標的タンパク質のPPxY(またはそれに類似した)モチーフを認識する。
発現
ヒトのNEDD4L遺伝子は染色体上18q12.31に位置し、38個のエクソンからなり、複数のスプライスバリアントが転写される。脳、肺、腎臓で発現するタンパク質はC2ドメインを含んでいる。NEDD4Lには3つの主要なアイソフォームが存在する。アイソフォームIはエクソン1の開始コドンから始まる新奇C2ドメインを含む。アイソフォームIIは保存された完全なC2ドメインを含み、アイソフォーム1の開始コドンよりも上流の代替的開始コドンから始まる。アイソフォームIIIはエクソン2a-3のスプライシングのためC2ドメインを含まない。アイソフォームIは腎臓と副腎で多く発現している一方、アイソフォームIIは肺で支配的ある。NEDD4-2特異的抗体はほとんどの組織で110-115 kDaの2種類を認識するが、そのうちの1つは組織によって大きさが異なる。
機能
NEDD4LはE3ユビキチンリガーゼであり、ユビキチン結合酵素からチオエステルの形でユビキチンを受け取り、その後特異的基質へと転移する。
In vivoでは、NEDD4-2は肺と腎臓でENaCを、腎臓でNCCといくつかのNavを調節する。また、EGFR、TGFβ受容体、そしてWntシグナル経路を調節することが示されている。NEDD4Lは、ウイルスタンパク質のユビキチン化を介してウイルスの出芽や潜伏過程へ関与することが示唆されている。In vitroのデータではNEDD4-2はいくつかのイオンチャネルや輸送体など他の多くのタンパク質に調節に関与することが示唆されているが、これらの結果のほとんどはin vivoでの検証は行われていない。
調節
NDFIP1、NDFIP2タンパク質はNEDD4-2に結合し、その活性および/または基質との相互作用を調節する。キナーゼSGK1とAKTによる、インスリンとアルドステロンシグナルに応答したNEDD4-2のリン酸化は14-3-3タンパク質との結合をもたらす。NEDD4-2への14-3-3の結合は、基質(ENaCのサブユニットなど)に結合してユビキチン化を行う活性を阻害する。NEDD4-2の自己ユビキチン化とUSP2-45による脱ユビキチン化によってNEDD4-2タンパク質の安定性が調節されていることが知られている。
臨床的意義
NEDD4Lは腎臓のENaCとNCCの重要な調節因子であり、この経路の機能不全は高血圧と関連している。リドル症候群では、ENaCのサブユニットの遺伝子変異によってNEDD4Lが結合できなくなっているため、このような症状がみられる。マウスでは、NEDD4-2の欠失は肺でのENaCの細胞表面での発現と活性を増加させ、肺水の早期除去、気道の乾燥、肺の炎症、周産期致死が引き起こされる。
マウスの尿細管特異的なNEDD4-2の欠失は、ENaCとNCCの発現上昇を引き起こす。ENaCとNCCの調節における重要な機能を有していることと一致して、NEDD4Lの多型は特定の人口集団において本態性高血圧と関連している。マウスでの神経特異的なNEDD4-2の欠失は軸索の分枝の欠陥を引き起こす。NEDD4-2ノックアウトマウスから単離された胎児皮質ニューロンは電位依存性ナトリウムチャネルによる電流の調節に欠陥を示し、神経障害性疼痛の動物モデルではNEDD4-2の発現がダウンレギュレーションされていることが判明している。またNEDD4-2の欠乏は、後根神経節ニューロンの過興奮を引き起こし、神経障害性疼痛に寄与する。
相互作用
NEDD4LはSCNN1Aと相互作用することが示されている。
出典
関連文献